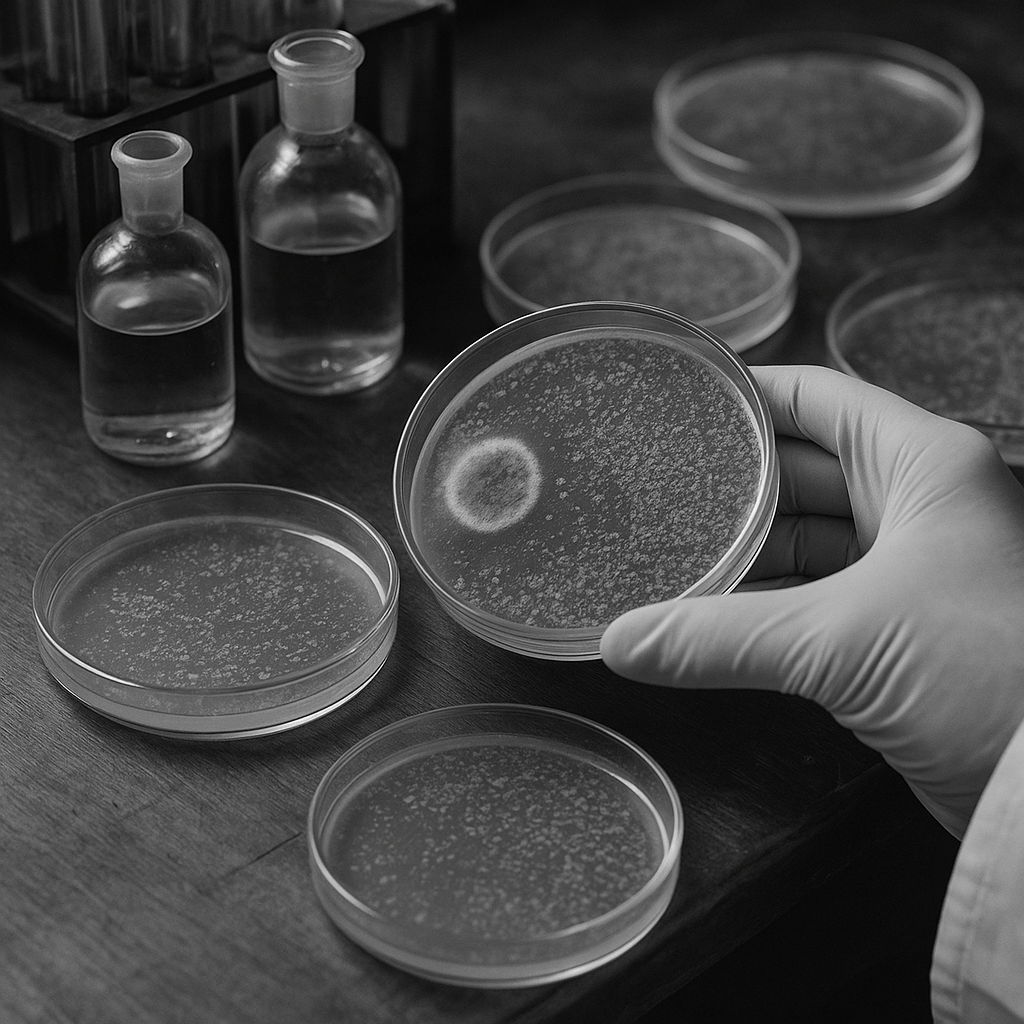

🔎💡Svět kolem nás by vypadal úplně jinak, kdyby se věci vždy řídily plánem. Mnoho zásadních vynálezů totiž vzniklo ne díky přesným výpočtům, ale díky nečekaným náhodám, omylům a malým katastrofám v laboratořích.
Pojďme se podívat na pět geniálních vynálezů, které vznikly úplně jinak, než jejich autoři zamýšleli a přesto navždy změnily svět medicíny, technologie i každodenní život.
5. místo Rentgenové záření🩻
V roce 1895 fyzik Wilhelm Conrad Röntgen pracoval s tzv. katodovými paprsky (první verze dnešní elektronky).
?JAK SE TO STALO ?
🔍 Záhadné světélkování
Na stole od trubice několik metrů daleko ležel fluorescenční papír. A i přes černý obal začal záhadně svítit. Röntgen si uvědomil, že světlo z trubice nemohlo uniknout, ale něco ten papír přesto rozsvítilo
🦴 Paprsky procházejí předměty – i lidskou rukou
Když mezi papír a trubici dal různé předměty, zjistil, že některé propouštějí záření více a některé méně. A když dal mezi ně svou ruku, na fluorescenčním papíru viděl stíny kostí. To byl šokující objev, že něco neviditelného umělo „nahlédnout“ do těla.
📷 3. První rentgenová fotografie v historii
První snímek, který Röntgen udělal, byla ruka jeho manželky, na které byla vidět její kostra a prsten. Když to uviděla, údajně řekla:
„Viděla jsem svou smrt.“
?Proč „X-paprsky“?
Röntgen nevěděl, co přesně objevil, proto nové záření pojmenoval „X“ jako něco neznámého. Později se tomu začalo říkat rentgen na jeho počest.

4. místo Pacemaker🔋❤️
V roce 1958 pracoval americký inženýr Wilson Greatbatch na elektronickém přístroji určeném k měření srdečního rytmu.
?JAK SE TO STALO ?
🔑Klíčové přehmátnutí
Do obvodu měl vložit odpor s určitou hodnotou, ale sáhl vedle a omylem vzal úplně jiný odpor. Když zařízení zapnul, čekal plynulý signál. Jenže obvod se začal chovat zvláštně. Nevydával stabilní šum, ale pravidelné rytmické pulzy. Greatbatch zpozorněl. Pulzy byly pomalé, klidné… a zněly jako lidský srdeční tep.
💡Uvědomění
V tu chvíli si uvědomil, že má před sebou něco víc než elektrickou chybu. Náhoda mu ukázala princip zařízení, které dokáže napodobit tep srdce a řídit jeho rytmus. Z nedopatření vznikl nápad na první implantovatelný kardiostimulátor.
🗓️Doba než se vše povedlo realizovat
Trvalo několik let, než se nápad převedl do reálné podoby, ale základy byly položené právě touhle chybou. Dnes díky pacemakerům žijí miliony lidí déle a bezpečněji a to vše kvůli jednomu jedinému špatně zvolenému odporu.

3. místo Mikrovlnná trouba⚡️
Objev mikrovlnné trouby nezačal v kuchyni, ale v laboratoři firmy Raytheon, kde inženýr Percy Spencer pracoval s radarovou technologií.
?JAK SE TO STALO ?
🍫Důležitá svačina
Jednoho dne stál u zapnutého magnetronu, což je zařízení, které vytváří silné mikrovlnné záření pro radary. A tehdy si všiml něčeho zvláštního. V kapse měl čokoládovou tyčinku… a ta se mu najednou roztekla. Spencer věděl, že v místnosti není horko. Čokoláda musela roztát kvůli něčemu jinému — kvůli tomu, co vycházelo z magnetronu.
👨🔬Začal experimentovat
Položil před magnetron kukuřičná zrna. Za pár okamžiků začala praskat a vznikl popcorn. Pak přišlo na řadu vejce — nejenže se zahřálo, ale dokonce vybouchlo.
💡Uvědomění
V tu chvíli bylo jasné, že objevil něco unikátního: mikrovlnné záření dokáže rychle ohřívat potraviny zevnitř.
🔧Realizace
V roce 1947 vznikla první mikrovlnná trouba — obrovská, těžká a drahá. Ale princip byl stejný jako tehdy v laboratoři. Dnes je mikrovlnka běžnou součástí domácností po celém světě. A mohla za to jedna nenápadná, neplánovaná čokoládová nehoda.

2. místo Post-it papírky🔖
Příběh Post-it papírků začíná v laboratoři firmy 3M, kde chemik Spencer Silver pracoval na vývoji velmi silného lepidla. Cílem bylo vytvořit něco, co bude držet pevně.
?JAK SE TO STALO ?
Špatná směs🧪
Jenže výsledek byl pravý opak: Silver vyrobil lepidlo, které drželo jen trochu — sice lepilo, ale dalo se kdykoli snadno odlepit bez stop.
Výsměch😁
Pro většinu lidí by to byl neúspěch. Slabé lepidlo? K čemu by to bylo dobré? Silver se snažil kolegům vysvětlit, že má potenciál — nikoho to nezajímalo.
Čas a jeho síla⏱️
Až o několik let později přišel kolega Art Fry s problémem: ve zpěvníku v kostele mu neustále vypadávaly záložky. Chtěl papírek, který bude držet, ale nezničí stránky. Vzpomněl si na Silverovo „slabé“ lepidlo — a zrodily se Post-it papírky.

1. místo Penicilin💊
V roce 1928 pracoval bakteriolog Alexander Fleming na studiu stafylokokových bakterií.
?JAK SE TO STALO ?
Zvláštní bariéra👀
Po návratu z dovolené si Fleming všiml: na jedné misce byla plíseň — a kolem ní čisté místo bez bakterií. Mikroorganismy se plísni „vyhýbaly“.
Zjištění🔬
Plíseň produkovala látku, která zabíjela škodlivé bakterie, ale nepoškozovala lidské buňky. Nazval ji penicilin. Nevěděl, že právě objevil první antibiotikum.